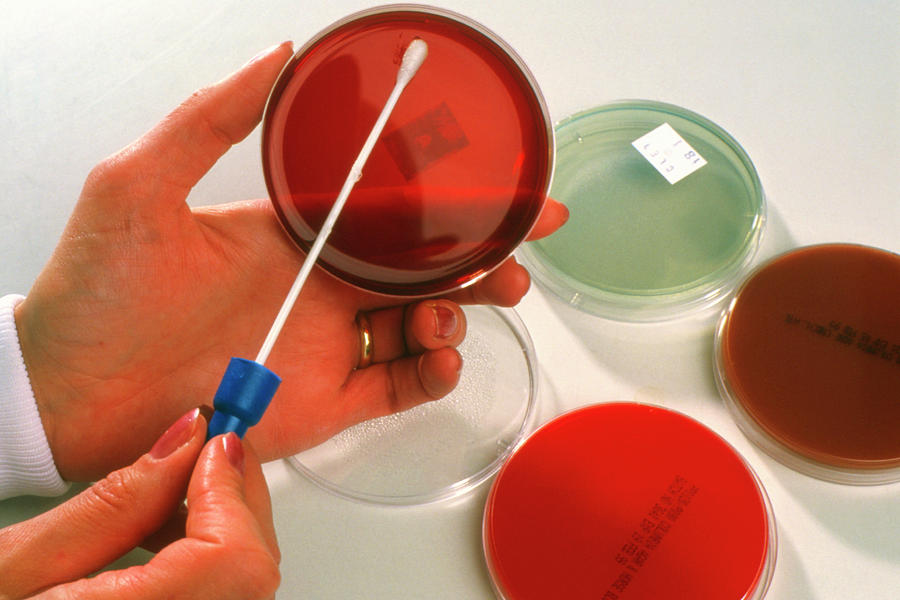

Keeping patient at centre we do provide accurate and reliable report in clinical diagnosis, we accept all kind of sample of huma origin
Culturing of Bacterial Pathogen and sensitivity
Culture fungal Pathogens and sensitivity
Un-aerobic culture and sensitivity test
Initial pathogen Identification test
Made with ❤ by Yashaswi Bhavah | Kamlesh Kurankar – 8070011222 | WhatsApp | Website | Email